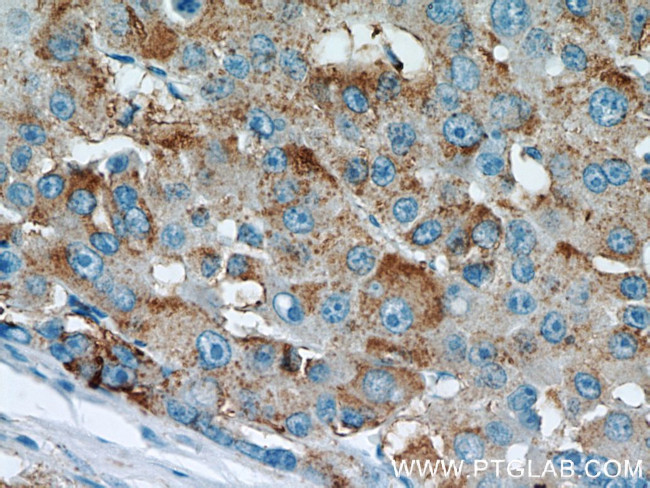
Willin Antibody in Immunohistochemistry (Paraffin) (IHC (P))
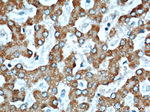
Willin Antibody in Immunohistochemistry (Paraffin) (IHC (P))

Search
Proteintech
Willin Polyclonal Antibody
{{$productOrderCtrl.translations['antibody.pdp.commerceCard.promotion.promotions']}}
{{$productOrderCtrl.translations['antibody.pdp.commerceCard.promotion.viewpromo']}}
{{$productOrderCtrl.translations['antibody.pdp.commerceCard.promotion.promocode']}}: {{promo.promoCode}} {{promo.promoTitle}} {{promo.promoDescription}}. {{$productOrderCtrl.translations['antibody.pdp.commerceCard.promotion.learnmore']}}
产品信息
21039-1-AP
种属反应
宿主/亚型
分类
类型
抗原
偶联物
形式
浓度
规格
纯化类型
保存液
内含物
保存条件
运输条件
产品详细信息
Although willin is found in the cytoplasm and membrane, it localizes to the nuclei of almost all tumors. This antibody was raised against the C-terminal region of human FRMD6 protein and is expected to recognize the endogenous FRMD6.
Immunogen sequence: LDMDQLEKR SRASGSSAGS MKHKRLSRHS TASHSSSHTS GIEADTKPRD TGPEDSYSSS AIHRKLKTCS SMTSHGSSHT SGVESGGKDR LEEDLQDDEI EMLVDDPRDL EQMNEESLEV SPDMCIYITE DMLMSRKLNG HSGLIVKEIG SSTSSSSETV VKLRGQSTDS LPQTICRKPK TSTDRHSLSL DDIRLYQKDF LRIAGLCQDT AQSYTFGCGH ELDEEGLYCN SCLAQQCINI QDAFPVKRTS KYFSLDLTHD EVPEFVV (359-622 aa encoded by BC029870 )
靶标信息
The protein encoded by this gene interacts with signaling pathways to coordinately regulate cell growth, cell proliferation, apoptosis, autophagy, and cell migration. This tumor suppressor also enhances retinoblastoma 1 gene expression in cancer cells. Alternative splicing results in multiple transcript variants encoding distinct isoforms.
仅用于科研。不用于诊断过程。未经明确授权不得转售。
篇参考文献 (0)
生物信息学
蛋白别名: 4.1 ezrin radixin moesin (FERM)-containing protein; expanded homolog; FERM domain-containing protein 163SCII; FERM domain-containing protein 6; FERM-domain-containing protein 163SCII; MGC17921; unnamed protein product; Willin
基因别名: 2610019M19Rik; 4930488L10Rik; AW212977; c14_5320; C14orf31; EX1; FRMD6; Willin
UniProt ID: (Human) Q96NE9, (Mouse) Q8C0V9
Entrez Gene ID: (Human) 122786, (Rat) 257646, (Mouse) 319710